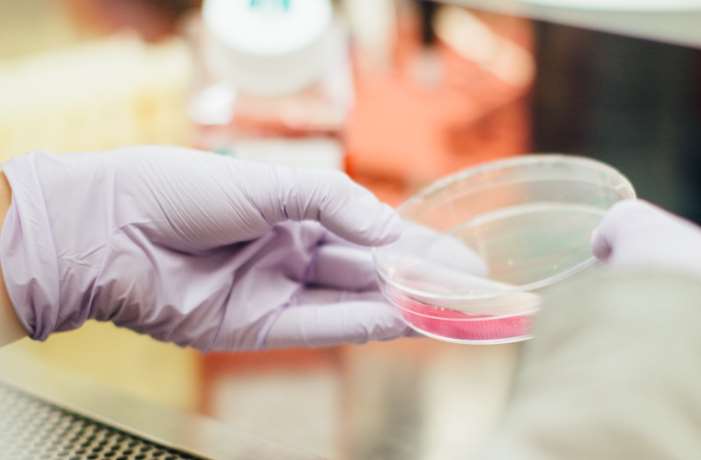

- Investigadores del IMIBIC, Reina Sofía y UCO descubren nuevas dianas terapéuticas y marcadores para el diagnóstico del cáncer de próstata.
- Los estudios demuestran que varios componentes de los sistemas endocrinos de la somatostatina y la ghrelina podrían ser nuevos biomarcadores de la presencia y agresividad de este tumor.
A pesar de que el cáncer de próstata es el segundo tipo de tumor sólido más frecuente entre los hombres, los biomarcadores disponibles para su diagnóstico y las posibilidades terapéuticas son muy limitadas.
 Ahora, investigadores del Instituto Maimónides de Investigación Biomédica de Córdoba (IMIBIC), el Hospital Universitario Reina Sofía y la Universidad de Córdoba (UCO), han abierto una esperanza tras descubrir que varios componentes de los sistemas endocrinos de la somatostatina y la ghrelina podrían representar nuevas dianas terapéuticas y marcadores tumorales para el diagnóstico del cáncer de próstata.
Ahora, investigadores del Instituto Maimónides de Investigación Biomédica de Córdoba (IMIBIC), el Hospital Universitario Reina Sofía y la Universidad de Córdoba (UCO), han abierto una esperanza tras descubrir que varios componentes de los sistemas endocrinos de la somatostatina y la ghrelina podrían representar nuevas dianas terapéuticas y marcadores tumorales para el diagnóstico del cáncer de próstata.
Recientemente, se ha demostrado que la aparición de moléculas atípicas favorece el desarrollo y la progresión del cáncer, pudiendo representar nuevas dianas terapéuticas para el control de la enfermedad o marcadores de la presencia y pronóstico de esta patología.
Estudio del “splicing alternativo”
Estas moléculas aparecen por diversos procesos, incluyendo el “splicing alternativo”, por el que un gen concreto deja de expresarse de manera normal y puede generar diferentes variantes o la mayor expresión de determinadas proteínas que están relacionadas con una mayor agresividad tumoral.
El grupo Hormonas y Cáncer del IMIBIC, dirigido por los profesores Raúl M. Luque y Justo P. Castaño, investiga desde hace varios años el papel de diversos componentes y variantes del splicing alternativo de los sistemas de regulación ghrelina y somatostatina en diferentes tumores de carácter endocrino.
Los resultados obtenidos en estos estudios demuestran que las formas de splicing alternativo In1-ghrelina y sst5TMD4 y el receptor sst1 se expresan de manera muy prominente en cáncer de próstata, y especialmente en aquellos pacientes con peor pronóstico clínico, pudiendo representar nuevos biomarcadores de la presencia y agresividad de la enfermedad.
Además, mediante la realización de ensayos in vitro e in vivo se ha observado que la presencia de estas moléculas incrementa la malignidad y agresividad de las células tumorales a través del aumento de la capacidad proliferativa y/o migratoria de éstas.
Estos hallazgos del grupo de Hormonas y Cáncer del IMIBIC, el Departamento de Biología Celular, Fisiología e Inmunología de la UCO y el CIBER de Obesidad y Nutrición (CIBERobn), liderados por el doctor Raúl M. Luque, en colaboración con investigadores clínicos del Hospital Reina Sofía, se han publicado en tres prestigiosas revistas científicas internacionales en los campos de biología celular y oncología: FASEB Journal, Molecular Cancer y Prostate.
Los resultados de estos estudios amplían el conocimiento actual sobre la biología del cáncer de próstata y abren nuevas vías de estudio sobre posibles dianas terapéuticas y de diagnóstico de esta enfermedad.